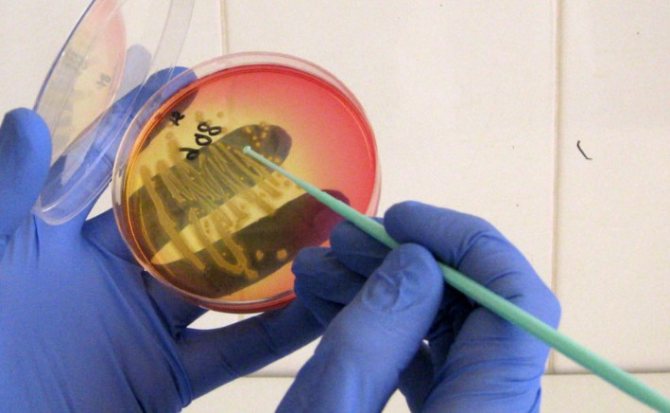
image

Дерматология
Игорь Поздеев
2323
Не все изменения, связанные с кожей мужского пениса, обязательно связаны с какой-то патологией, но и исключать такой вариант нельзя. Часто совершаемая ошибка – это самолечение, которое не проясняет причины появлений тех или иных дефектов и болячек, а вот вред может быть нанесён реальный. Когда появляются белые точки на члене, не надо гадать или ударяться в панику, самое разумное решение – это визит к врачу.
Белые пятна на члене при витилиго
Часто диагностируемой причиной появления белых пятен на половом члене является витилиго.
Для заболевания характерна недостаточность продуцирования меланоцитов.
Это приводит к нехватке в организме пигмента меланина, отвечающего за цвет кожи, волос, радужку глазного яблока.
В начале развития болезни кожные покровы приобретают розоватый оттенок.
После чего отдельные участки начинают обесцвечиваться (бледнеть).
Прогрессирование болезни приводит к формированию белых пятен различной формы и размеров, отличающихся четкими контурами.
Развитие витилиго на половом члене проходит в несколько этапов:
- На любом участке полового члена либо коже, окружающей орган, возникают бледно-розового оттенка пятна.
- Спустя некоторое время пятна обесцвечиваются и становятся в несколько раз больше в размерах.
- Склоны к слиянию, образовывая огромные обесцвеченные участки.
Дополнительными симптомами являются сухость в пораженных участках, снижение чувствительности.
Иногда при данной патологии возникает раздражение обесцвеченных участков, вследствие чего возникает гиперемия и шелушение.
Также высока вероятность повреждения пятен и занесения инфекционного возбудителя, что может ухудшить как физическое, так и психологическое состояние.
К сожалению, на сегодняшний день не существует методики, которая смогла бы устранить клинические признаки болезни.
Как правило, основное лечение заключается в предупреждении дальнейшего прогрессирования болезни.
В частных клиниках могут предложить пересадку меланоцитов, искусственно произведенных, в пораженную область.
Основу терапии составляют – антиоксиданты, препараты для стимуляции иммунной системы, лазерное излучение или ПУВА-терапию.
Механизм возникновения
В некоторых случаях появление белых пятен на коже гениталий является нормой. Например, такая картина часто наблюдается у подростков в период полового созревания, что связано с гормональной перестройкой организма. У мужчин же белые точки на члене могут возникнуть по причине недостаточного ухода за половыми органами либо из-за развития определённых заболеваний. В последнем случае появление сыпи может сопровождаться болезненностью, зудом, а также дискомфортом при половом контакте. В такой ситуации мужчине необходимо обязательно обратиться к специалисту для проведения диагностики и последующего лечения основной патологии.
Причины и провоцирующие факторы
Возникновение белых пятен на половом стволе может быть обусловлено несколькими факторами. Чаще всего, это происходит по следующим причинам:
- Закупорка сальных протоков. Это может быть вызвано усиленным функционированием сальных желёз, что приводит к закрытию протоков, в результате чего на поверхности члена образуются белые пятна. Процесс нередко сопровождается появлением неприятного запаха. Сальные железы также очень часто перекрываются остатками смегмы, которую большинство мужчин практически не удаляет. При несоблюдении правил гигиены кожа в области половых органов начинает шелушиться и чесаться.
- Патогенные микроорганизмы. Размножение бактерий также обусловлено нарушением гигиенических норм. В этом случае смегма, скопившаяся под крайней плотью, представляет собой неплохую питательную среду для роста болезнетворной флоры. Результатом всего этого становится появление белых пупырышков.
- Кандидоз. Патология больше всего известна как молочница. Этому недугу подвержены мужчины, имевшие половой контакт с заражённой партнёршей. При этом проявляется болезнь не сразу, поскольку грибок Кандида может долгое время находиться в спящем состоянии и активизироваться только после наступления определённых условий: длительный приём антибиотиков, стрессы, резкое снижение иммунитета. На этом фоне у мужчины возникают белые бугорки на головке члена, сильный зуд, покраснение кожных покровов, творожистые выделения. От пениса может исходить специфический кислый запах.
- Венерические болезни. Появление белой сыпи характерно для таких патологий, как хламидиоз, герпес генитальный, гонорея, сифилис. Процесс, как правило, сопровождается резями в мочеиспускательном канале, сильным зудом, характерными выделениями жёлто-зелёного либо зелёного цвета. При этом может ощущаться рыбный или гнилостный запах.
- Вирус папилломы человека (ВПЧ). Заражение происходит после незащищённого полового акта с носителем заболевания, в результате чего на члене возникают остроконечные кондиломы белого цвета.
- Аллергические реакции. Мелкие белые или красные высыпания на головке пениса могут быть следствием активации гистаминов. Аллергию могут вызвать определённые продукты питания, латекс, синтетика, бытовая химия, лекарственные препараты и так далее.
- Гранулы Фордайса. Так именуются себорейные кисты, представляющие собой видоизменённые сальные железы. При этой патологии белые высыпания обычно локализуются на поверхности пениса, не распространяясь на головку и крайнюю плоть. Пятна характеризуются отсутствием зуда, болезненности и воспаления. Гранулы Фордайса не считаются серьёзной проблемой, поскольку здоровью мужчины они не угрожают.
- Баланопостит. Появляются пятна белого или красного цвета, которые могут доставлять дискомфорт, зудить и болеть. Развивается воспаление крайней плоти и головки члена, появляется отёчность, жжение и неприятный резкий запах.
Последствия, которые могут вызвать белые пятна головке члена
Появление каких-либо высыпаний на гениталиях — чаще всего неблагоприятный признак, говорящий о наличии заболевания или являющийся его предвестником. Поэтому наличие образований в области полового члена – повод для немедленного посещения венеролога, который правильно поставит диагноз и назначит адекватную терапию.
Однако белые точки на головке чаще всего не являются патологической проблемой и не требуют лечения. Важно вовремя дифференцировать физиологические высыпания от инфекционных (в том числе венерических) проявлений.
Такая симптоматика, как белые пятна на головке полового члена, не является редким случаем, а говорит о серьезных проблемах. Данному заболеванию подвергнуты мужчины от 30 лет, чаще всего симптоматика имеет повторяющийся характер и может негативно влиять на мужское здоровье.
В большинстве случаев данные симптомы являются следствием грибковой инфекции, от которой довольно не просто избавиться, если оставить болезнь на самотёк, вы и ваш половой партнёр постоянно будете страдать от наличия данного заболевания, что усложнить и принесёт неприятности в вашу половую жизнь и может очень негативно повлиять, например, на решение пары иметь детей.
Для нормального зачатия, ребёнок должен развиваться в среде, в которой грибковой инфекции нет места. Если супруги не избавились от болезни до зачатия, им всё равно придется лечиться во время беременности, что негативно может повлиять на плод. Если болезнь начнёт прогрессировать, она может непосредственно повлиять на развитие бесплодия у мужчин.
В любом случае не пытайтесь самостоятельно вылечить болезнь или поставить себе неверный диагноз.
Причины появления
Для любого мужчины крайне важно следить за здоровьем, а в особенности уделять не малую долю внимания половым органам. Новообразования на члене не всегда является плохим признаком, но это не значит, что им не стоит уделять должного внимания.
Иногда серьёзные заболевания начинаются с простых небольших белых точек. Урологи выявляют несколько возможных причин появления этого недуга.
К ним относятся:
- Недостаточное соблюдение гигиены интимных участков тела. Кожа головки члена очень чувствительна и имеет множество секретовыделяющих клеток. Они постоянно выделяют спегму, которая быстро подсыхает и сопутствует развитию воспалений и иных кожных заболеваний. Часто из-за этого наблюдается появление белых точек на головке члена.
- Гранулы фордайса – это образования белого оттенка на мужском половом органе без зуда и боли. Они появляются сами по себе во время полового созревания юноши. Происходит так, потому что в молодом организме появляется резкий приток тестостерона, а он способствует ускоренному функционированию сальных желёз. Гранулы фордайса не является болезнью и не требует лечения.
- Незащищённый секс, повлёкший за собой инфекционное заболевание половых органов. Например, в симптоматике гонореи, генитального герпеса, хламидиоза и сифилиса есть красно белые точки на головке и крайней плоти. Чтобы убедиться в правильности диагноза рекомендуется обязательно обратиться к медицинскому специалисту.
- Кандидоз может вызывать у мужчин белые новообразование на головке фаллоса.
- Иногда появление белых точек является процессом физиологическим и абсолютно нормальным. Это могут быть небольшие видоизменения в фолликулах волосяного покрова либо сальных желёз. Ни то, ни другое не требует никаких вмешательств, пока не появится видимое раздражение или воспаление.
Пятна на члене при невусе Сеттона
Совместно с появлением доброкачественного новообразования (родинка) происходит обесцвечивание участка кожи пениса вокруг невуса, что визуально имеет сходство с витилиго.
Формируется единичным элементом, реже возникают множественные родинки.
Точная причина развития невуса Сеттона на сегодняшний день не установлена.
Однако практически в 60% из всех случаев сопутствующим заболеванием является витилиго.
Также ученные отмечают связь патологии с воздействием ультрафиолетового излучения.
При обнаружении схожих симптомов необходимо обратиться к дерматоонкологу для проведения дифференциальной диагностики с меланомой (злокачественным образованием).
Этапы формирования родинки:
- Первоначально возникает невус.
- Спустя некоторое время вокруг новообразования формируются обесцвеченные участки кожных покровов.
- Иногда перед появлением ободка возникает гиперемия.
Лечение патологических процессов отсутствует, состояние кожи полового члена находится под пристальным контролем врача, который проводит регулярные осмотры пораженного участка.
Это позволит исключить раковые процессы.
Также рекомендуется пациентам отказаться от длительного пребывания под открытыми солнечными лучами, использовать средства защиты от ультрафиолета.
Несоблюдение личной гигиены
Наиболее благоприятной причиной образования белых пятнышек в области полового члена является нарушение правил интимной гигиены.
Физиология мужчин такова, что в норме на головке у них открываются протоки специальных желез, продуцирующих смегму. Смегма – вещество, белесоватого цвета, которое имеет неприятный резкий запах. При регулярных водных процедурах данный секрет незаметен и не доставляет дискомфорта.
Однако при нарушении личной гигиены смегма скапливается на головке, образуя налет белого цвета, который образует пятнышки. От них исходит неприятный запах, однако субъективный ощущений нет. Наличие такого налета не является болезнью, однако становится предвестником будущих инфекций и воспалительных процессов в мочеполовой системе. Лечение в данной ситуации не назначают. Для исчезновения пятен достаточно регулярно принимать душ.
Симптомы
Высыпания на головке полового члена могут появляться вследствие поражения организма венерическими инфекциями и воспалительными заболеваниями мочеполовой системы.
Симптомы:
- зуд, не проходящий в течение недели и более;
- болевые ощущения в паховой области и внизу живота;
- наличие папулезных, возвышающихся над кожей высыпаний;
- общие явления интоксикации и инфицирования в виде слабости и повышения температуры;
- увеличение лимфатических узлов в паховой области или любых нескольких групп;
- болезненные ощущения в области высыпаний;
- изъязвления, не склонные к заживлению.
Наиболее частыми инфекциями, поражающими половой член, являются сифилис и гонорея.
Период полового созревания
В подростковом периоде в организме мальчика происходит множество изменений, в том числе, гормональные перестройки. Белые точки на головке члена возникают из-за нарушения работы желез. На половом члене (от головки до основания) начинает скапливаться секрет вследствие закупорки протоков, из-за чего образуются белые пятна.
Данное явление весьма распространенное и не требует лечения, так как при нормализации работы эндокринной системы в организме восстанавливается продукция и экскреция секрета желез. Однако посещение венеролога все же рекомендуется, так как пятна можно спутать с серьезными патологическими высыпаниями.
Белые пятна признак болезни, которую можно диагностировать. Занимаются лечением заболевания соответствующие специалисты – урологи и дерматовенерологи. В основном достаточно бывает осмотра на приеме у врача. Пациенту необходимо рассказать основные симптомы, не стесняясь и не скрывая, подробностей протекания болезни.
Кроме осмотра врач может взять соскоб и бакпосев на диагностику с целью правильной постановки диагноза. Только после установления диагноза врач может назначить соответствующее лечение.
Патологический процесс приводит к изменениям эпидермиса, его поражению.
Белые пятна на члене являются отличительной чертой патологии.
Склероатрофический лихен представляет собой не одну патологию, а различные болезни кожных покровов невыясненной этиологии, относится к лишаям.
Спровоцировать появление данной разновидности лишая могут разные факторы.
Это аутоиммунные патологии, инфекционные заболевания мочеполового тракта, в частности ЗППП, дисфункции щитовидной железы, сахарный диабет и другие.
Клинические признаки выглядят следующим образом:
- На любом участке кожи пениса возникают элементы в виде белых пятен и папулезной сыпи, ограниченные от здоровой кожи.
- Первые высыпания имеют размеры до 5 мм.
- Со временем папулы соединяются и образуют бляшки, возвышающиеся над уровнем кожных покровов.
- У пациента повышается сухость на пораженном участке, появляются неприятные ощущения.
- При поражении головки пениса появляется голубоватый оттенок, невозможно определить границы сыпи.
В отдельных случаях, при стремительном прогрессировании болезни, могут развиваться серьезные последствия в виде:
- сужения крайней плоти (требуется хирургическое вмешательство);
- сужение губок мочеиспускательного канала;
- образование трещин.
Вылечить данную разновидность лишая медикам не удается.
Проводится симптоматическое лечение, направленное на устранение неприятных признаков.
Местная терапия с использованием кортикостероидов назначается при наличии бляшек.
Применяются противомалярийные препараты, а также средства для улучшения кровоснабжения пениса.
Основное лечение направлено на устранение причины патологических процессов.
Белые пятна на коже члена могут быть последствием травм или оперативных вмешательств.
К примеру, при удалении кондилом или доставляющих дискомфорт невусов.
При заживлении различного рода повреждений происходят регенеративные процессы, вследствие которых формируются рубцы, состоящие из коллагена (структурного белкового соединения).
После травмы и ее заживлении на половом члене появляются рубцы, оттенок которых отличается от окружающих здоровых тканей и имеет вид белого пятна.
Заболевание характеризуется воспалением волосяного мешочка, проявляется на участках крайней плоти пениса.
Заболевание возникает в результате снижения иммунитета, при расстройствах обменных процессов, на фоне сахарного диабета.
Также вследствие нарушения привычной флоры при длительной антибиотикотерапии.
Развивается патологический процесс с появления гиперемии и инфильтрата в пораженном месте.
Далее образовывается бугорок, внутри которого содержится гной, сверху покрыт коркой, имеющей красно – белый оттенок.
Гнойное образование вскрывается, формируя ранку.
После заживления патологического процесса может оставаться рубец, при поверхностном поражении следы отсутствуют.
Длительность заболевания и заживление составляет до 1-1,5 недели.
При обнаружении любых патологических явлений на половом члене следует обратиться к урологу.
После визуального осмотра и проведения лабораторной диагностики врач может перенаправить пациента к другому специалисту – дерматовенерологу или онкологу.
Диагностика состоит из следующих мероприятий:
- ПЦР (определяется патогенные микроорганизмы, применяется на ранних сроках болезни);
- дерматоскопия – проводится при подозрении на кожные патологии, в ходе исследования используются увеличительные приборы для лучшей визуализации возникшего белого пятна и его детального изучения;
- при подозрении на злокачественное образование проводится биопсия, для которой берут частицы клеточных структур или тканей из пораженного участка;
- при бактериальной инфекции выполняется бак посев, позволяющий определить наличие микроорганизмов, их концентрацию; выполняется антибиотикограмма для выявления чувствительности бактерий к антибактериальным препаратам.
Схема терапии полностью зависит от поставленного диагноза.
В первую очередь пациенту необходимо следить за гигиеной половых органов и принимать ежедневно душ или другие водные процедуры.
Медикаментозная терапия может включать использование антибиотиков, противомикробных средств, противогрибковых, витаминных комплексов, антигистаминных препаратов, кортикостероидов и прочих лекарств.
При появлении пятен на члене обращайтесь к автору этой статьи – дерматовенерологу в Москве с многолетним опытом работы.
Во избежание появления белой сыпи на половых органах мужчине не следует забывать о некоторых простых правилах:
- 1. Следует носить качественное белье из натуральных материалов. Оно должно свободно сидеть на теле и не прилегать к коже слишком плотно.
- 2. Необходимо регулярно уделять время гигиеническим процедурам. Для мытья рекомендуется использовать специальные средства для поддержания интимной гигиены.
- 3. Нужно предохраняться презервативами. В большинстве случаев белые образования на члене возникают по причине заражения инфекциями, передающимися половым путем.
- 4. Следует регулярно посещать медицинские учреждения. Обследоваться в профилактических целях нужно хотя бы один-два раза в год. Многие опасные заболевания не проявляются до тех пор, пока не приобретут острую или хроническую форму.
Следует помнить, что некоторые патологии, из-за которых появляются белые пятна на половых органах у мужчин, смертельны, лечить их надо вовремя.
Диагностические мероприятия и терапия заболеваний полового члена
- визуальный осмотр;
- исследование под кольпоскопом;
- взятие анализов крови, мочи, выделений из уретрального канала и с поверхности полового члена;
- УЗИ пениса и органов малого таза;
- биопсия.
Симптомы ЗППП
30.03.2018
5 мин.
Белые точки на половом члене могут появиться по разным причинам, в том числе из-за недостаточного или неправильного ухода за собой. Также маленькие пятна могут являться симптомом какого-то серьезного заболевания. Лечение будет зависеть от результатов диагностики.
Чаще всего мужчине необходимо пересмотреть то, как он заботится о своем теле, уделить большее внимание гигиене, качеству используемого белья и косметики.
Если же причиной появления точек на половом члене стала болезнь, то ее лечат с помощью медикаментозных препаратов — таблеток, порошков, мазей, а также народных средств.
К основным причинам появления белых точек на половом члене у мужчин относят:
- Недостаточную гигиену тела. Если вовремя не уделять внимание мытью половых органов, то на них будет скапливаться большое количество смегмы. Она начнет подсыхать на коже, отчего и образуются белые маленькие пятна.
- Ношение белья из некачественных тканей. Синтетическая ткань не пропускает воздух, отчего сальные железы начинают работать активнее. Во время их активной работы выделяются вещества, которые могут провоцировать появление точек на поверхности пениса.
- Использование неподходящих моющих средств. Некоторые средства не удаляют грязь с половых органов полностью. Из-за остатков смегмы, спермы, других выделений, кусочков отторженного эпителия могут появляться белые пятна.
Если точки не проходят длительное время несмотря на соблюдение правил гигиены, ношение качественного белья и смену моющих средств, то следует посетить медицинское учреждение.
В некоторых ситуациях образования на члене указывают на наличие развивающегося заболевания.
При этом часто появляются и другие симптомы, свойственные той или иной патологии: выделения, налет, зуд, жжение, шелушение, боль, дискомфорт и тому подобное.
| Заболевание | Описание и характеристика | Другая симптоматика | Фото |
| Молочница | Болезнь характеризуется размножением грибка кандида. Патология дает о себе узнать не сразу, поэтому многие пациенты обращаются к врачу в уже запущенной стадии диагноза | Наличие резкого неприятного запаха, зуд, жжение, затрудненное мочеиспускание, воспаление головки | |
| Гранулы Фордайса | Также называются себорейными кистами. Представляют собой видоизмененные сальные железы. Обычно белая сыпь распространяется по члену, но не затрагивает крайнюю плоть или головку. Пятна не болят, не зудят, не воспаляются. Заболевание считают лишь косметическим изъяном, здоровью пациента ничего не угрожает | Других симптомов нет | |
| Папилломавирусная инфекция | Возбудителем является вирус папилломы человека. Обычно образования имеют розовый цвет, но в некоторых ситуациях отмечают появления белых кондилом или кондилом телесного оттенка | Кровоточащие язвы, боли при дефекации или мочеиспускании, сильный зуд | |
| Баланопостит | У мужчины воспаляется половой член: головка и крайняя плоть. Появляются пятна красного и белого цвета. Они могут болеть, зудиться, приносить дискомфортные ощущения | Отек, болевые ощущения, резкий неприятный запах, жжение, сильный зуд | |
| Генитальный герпес | Генитальным герпесом называют одну из разновидностей герпесной инфекции. Для заболевания свойственно появление белых или телесных бугорков среднего размера. Они появляются и на половом члене, и в области анального отверстия, впоследствии превращаясь в язвы | Кожный зуд, боли в животе, увеличение лимфатических узлов, повышенная температура, слабость, |
Белые пятнышки на половом члене могут появиться и из-за других соматических заболеваний. Иногда образования возникают по причине снижения иммунитета, эндокринных заболеваний (сахарного диабета), наличия ВИЧ-инфекции, а также предраковых состояний. Влиять может и перемена климата, погоды, перепад температур.
Диагностикой заболевания занимается дерматовенеролог или уролог. Обследование начинается с визуального осмотра. После назначается ряд дополнительных анализов: общий анализ крови, бактериальный посев мочи, исследование внутреннего содержимого сыпи.
Исходя из результатов диагностики назначается лечение. Оно зависит от того, какой диагноз поставил врач. При половых инфекциях эффективна медикаментозная терапия. Реже доктор советует применение народных средств.
Чтобы избавиться от белых точек на пенисе, рекомендуется применять следующие мази:
- Ацикловир. Лекарство назначается при генитальном герпесе. Устраняет симптоматику и способствует скорому заживлению кожных покровов.
- Пимафуцин. Мазь используется при молочнице, убивает болезнетворную микрофлору и снимает красноту, зуд, болезненные ощущения.
- Левомеколь. Заживляет раздраженные участки кожи, способствует восстановлению кожных покровов.
- Солкосерил. Лекарство используется и в тех случаях, когда точки болят или зудят, и в тех, когда они дискомфорта не приносят.
- Пантенол. Способствует восстановлению поврежденных кожных покровов.
- Актовегин. Наносится на проблемные участки кожи в интимных местах, восстанавливая дерму.
- Оксолиновая мазь. Часто назначается при различных видах высыпаний, в том числе при кондиломах, герпесе, молочнице.
Применять мази без назначения специалиста не стоит. Важно помнить, что препараты устранят симптоматику и дискомфортные ощущения, но не вылечат пациента от заболевания.
Во избежание появления белой сыпи на половых органах мужчине не следует забывать о некоторых простых правилах:
- 1. Следует носить качественное белье из натуральных материалов. Оно должно свободно сидеть на теле и не прилегать к коже слишком плотно.
- 2. Необходимо регулярно уделять время гигиеническим процедурам. Для мытья рекомендуется использовать специальные средства для поддержания интимной гигиены.
- 3. Нужно предохраняться презервативами. В большинстве случаев белые образования на члене возникают по причине заражения инфекциями, передающимися половым путем.
- 4. Следует регулярно посещать медицинские учреждения. Обследоваться в профилактических целях нужно хотя бы один-два раза в год. Многие опасные заболевания не проявляются до тех пор, пока не приобретут острую или хроническую форму.
Следует помнить, что некоторые патологии, из-за которых появляются белые пятна на половых органах у мужчин, смертельны, лечить их надо вовремя.
- 1. Следует носить качественное белье из натуральных материалов. Оно должно свободно сидеть на теле и не прилегать к коже слишком плотно.
- 2. Необходимо регулярно уделять время гигиеническим процедурам. Для мытья рекомендуется использовать специальные средства для поддержания интимной гигиены.
- 3. Нужно предохраняться презервативами. В большинстве случаев белые образования на члене возникают по причине заражения инфекциями, передающимися половым путем.
- 4. Следует регулярно посещать медицинские учреждения. Обследоваться в профилактических целях нужно хотя бы один-два раза в год. Многие опасные заболевания не проявляются до тех пор, пока не приобретут острую или хроническую форму.
Следует помнить, что некоторые патологии, из-за которых появляются белые пятна на половых органах у мужчин, смертельны, лечить их надо вовремя.
Патологический процесс приводит к изменениям эпидермиса, его поражению.
Белые пятна на члене являются отличительной чертой патологии.
Склероатрофический лихен представляет собой не одну патологию, а различные болезни кожных покровов невыясненной этиологии, относится к лишаям.
Спровоцировать появление данной разновидности лишая могут разные факторы.
Это аутоиммунные патологии, инфекционные заболевания мочеполового тракта, в частности ЗППП, дисфункции щитовидной железы, сахарный диабет и другие.
Клинические признаки выглядят следующим образом:
- На любом участке кожи пениса возникают элементы в виде белых пятен и папулезной сыпи, ограниченные от здоровой кожи.
- Первые высыпания имеют размеры до 5 мм.
- Со временем папулы соединяются и образуют бляшки, возвышающиеся над уровнем кожных покровов.
- У пациента повышается сухость на пораженном участке, появляются неприятные ощущения.
- При поражении головки пениса появляется голубоватый оттенок, невозможно определить границы сыпи.
В отдельных случаях, при стремительном прогрессировании болезни, могут развиваться серьезные последствия в виде:
- сужения крайней плоти (требуется хирургическое вмешательство);
- сужение губок мочеиспускательного канала;
- образование трещин.
Вылечить данную разновидность лишая медикам не удается.
Проводится симптоматическое лечение, направленное на устранение неприятных признаков.
Местная терапия с использованием кортикостероидов назначается при наличии бляшек.
Применяются противомалярийные препараты, а также средства для улучшения кровоснабжения пениса.
Основное лечение направлено на устранение причины патологических процессов.
Белые пятна на коже члена могут быть последствием травм или оперативных вмешательств.
К примеру, при удалении кондилом или доставляющих дискомфорт невусов.
При заживлении различного рода повреждений происходят регенеративные процессы, вследствие которых формируются рубцы, состоящие из коллагена (структурного белкового соединения).
После травмы и ее заживлении на половом члене появляются рубцы, оттенок которых отличается от окружающих здоровых тканей и имеет вид белого пятна.
Заболевание характеризуется воспалением волосяного мешочка, проявляется на участках крайней плоти пениса.
Заболевание возникает в результате снижения иммунитета, при расстройствах обменных процессов, на фоне сахарного диабета.
Белые пятна на члене при грибковой инфекции
Кандидоз полового члена передается от зараженного полового партнера.
Но иногда размножение грибковой микрофлоры происходит в результате несоблюдения ежедневной гигиены половых органов.
Предрасполагающим фактором развития кандидоза является снижение защитных сил организма.
Белые пятна на половом члене при молочнице не что иное, как белесый налет, возникающий в результате действия патогенных микроорганизмов.
Дополняет клинику такие признаки, как:
- ощущение жжения и зуда, возникающие преимущественно в районе головки пениса;
- гиперемия головки и крайней плоти полового члена;
- в процессе интимной близости появляются боли и дискомфорт;
- болезненность при опорожнении мочевого пузыря;
- во время мочеиспускания из уретры выделяется белое содержимое, по консистенции схожее на эякулят.
При наличии грибковой инфекции необходимо посетить уролога и сдать лабораторные анализы.
Это бактериологический посев для подтверждения возбудителя Candida и определения наиболее эффективной терапии.
Иногда специалист направляет пациента на консультацию к венерологу для проведения дифференциального диагноза с другими инфекциями, передающимися при половом контакте.
Для устранения болезни применяются противомикробные средства в виде мазей и таблеток.
Среди наиболее популярных местных средств Нистатин, Клотримазол, Кетоконазол.
Внутрь применяется Флуконазол. Совместно назначаются препараты для повышения иммунных сил организма.
Венерическое заболевание передается от инфицированного полового партнера и проявляется только спустя 14-21 день.
Первыми признаками сифилиса становится формирование на органах мочеполового тракта первичной сифиломы, представляющей собой язвенное образование с небольшим углублением внутри.
Также характерным отличием болезни является увеличение лимфатических узлов в паху.
Белые и красные пятна на половом члене при сифилисе могут возникать во втором периоде, когда возбудитель заболевания распространяется по всему организму.
Вторичный период сифилиса характеризуется появлением высыпаний не только на пенисе, но и по всему телу – нижних и верхних конечностях, плечах, спине, животе, грудной клетке.
Поставить точный диагноз сможет дерматовенеролог после проведения анализов.
Это ПЦР с поверхности сифиломы, бак посев (также определяет чувствительность микроорганизмов к антибиотикам).
Как правило, лечение состоит из использования антибактериальных средств пенициллинового ряда, к которым бледная спирохета сохраняет высокую чувствительность.
Реже применяются такие лекарства, как цефалоспорины, тетрациклин или эритромицин.
Дополнительно назначаются иммуномодуляторы.
Методы лечения на крайней плоти и на пенисе
Если симптоматика не исчезает, и к ней добавляются жжение, зуд, воспаление, покраснение, отечность боли, увеличение лимфоузлов, необходимо обратиться к специалисту. При появлении сыпи после полового контакта или прыщей на головке требуется консультация венеролога. В иных ситуациях целесообразно посетить уролога или дерматолога.
Диагностические мероприятия включают следующие процедуры:
- визуальный осмотр;
- бактериологическое исследование выделений из уретры и с поверхности полового члена;
- клинические анализы крови и мочи;
- забор материала на биопсию;
- УЗИ органов малого таза.
Для уточнения характера сыпи показано исследование ее содержимого. Анализ занимает от 1 до 10 дней, и только после получения результата врач составляет план терапии.
Белые точки на головке у мужчин требуют подробной диагностики. Объективный осмотр, анализы помогут врачу определить лечебную тактику.
Есть несколько способов лечения высыпаний. Выбор метода решения проблемы зависит от показаний и противопоказаний к нему, состояния больного, степени поражения члена.
Медикаментозный
Терапевтические мероприятия:
- В зависимости от картины анализа крови больному назначают противомикробные, противогрибковые, противовирусные препараты системно.
- Для купирования местного патологического процесса используют мази, спреи, кремы от точек.
- Для предупреждения присоединения вторичной бактериальной инфекции поверхность члена смазывают антисептическими средствами.
- Антигистаминные препараты помогают уменьшить зуд.
- Правильное питание, внимательный уход за членом — важные условия достижения результата.
- Препараты на основе гормонов.
Часто используемые средства для лечения белой сыпи, точек
| Название медикамента | Его описание |
| Ацикловир | Для лечения герпетических высыпаний. |
| Пимафуцин | Противогрибковое средство — тормозит размножение микроорганизмов, устраняет симптомы их жизнедеятельности. |
| Левомеколь, Пантенол, Актовегин | Заживляют поврежденную кожу члена при наличии белых язв. |
| Оксолиновая мазь | Борется с проявлениями молочницы, герпеса, папилломатоза. |
Расположение белых высыпаний, точек на чувствительных половых органах требуют назначения неагрессивных препаратов.
Нуждаетесь в совете опытного врача?
Получите консультацию врача в онлайн-режиме. Задайте свой вопрос прямо сейчас.
Задать бесплатный вопрос
Заниматься самолечением строго запрещается.
Хирургический
Хирургический способ лечения имеет два варианта:
- Белые бугорки, точки удаляются лазером. Малотравматичный, стерильный метод.
- Высыпания на члене иссекают скальпелем под местной анестезией.
К хирургическому лечению обращаются в таких случаях:
- Онкологическая природа белых образований. Опухоль иссекают из окружающих тканей с минимальной травматизацией. Место патологии заживает через 1-2 месяца.
- Точки достигают больших размеров, мешают человеку.
- Высыпания не поддаются медикаментозному лечению.
Операции на члене проводят после неудачной консервативной терапии. Врачи стараются убрать точки щадящим способом. Преимущество оперативного лечения — позволяет быстро избавляться от проблемы.
Другие
В начальный период высыпаний можно попробовать народные методы лечения. Мази, ванночки помогают избавиться от белых угрей, точек, расположенных по всему телу.
Популярные народные рецепты:
- Огуречные компрессы безопасны для пораженной кожи члена. Огурец натирают и заливают стаканом кипятка. Через 4 часа лечебный настой готов, можно делать примочки или ванночки.
- Ромашка и календула обладают противовоспалительными, ранозаживляющими свойствами. Травы берут в одинаковом количестве, заливают стаканом кипяченой воды. Через три часа можно смазывать пораженные области приготовленным настоем.
Если от народных средств белые высыпания на члене не проходят, нужно обратиться к врачу. Точки легко диагностируются, что упрощает лечение.
Статья прошла проверку
редакцией сайта
Остроконечные кондиломы
Второе в мире по распространенности заболевание, которые вызывается вирусом папилломы человека, чаще поражает женщин, однако мужчины не лишены риска заражения. Попадание вируса в организм возможно несколькими путями:
- половой;
- трансплацентарный;
- передача от матери ребенку при родах;
- заражения при переливаниях крови и использовании нестерильных инструментов;
- бытовой механизм, связанный с повреждениями слизистых и кожи.
Локализуются кондиломы, в основном, на половых органах, в том числе, поражая и головку. Одиночные новообразования имеют белесоватый цвет и едва различимы на слизистой оболочке. Высыпания сопровождаются зудом и воспалительными процессами.
Существует быстрая проверка происхождения белесоватого прыщика. Его нужно смазать 5% раствор уксусной кислоты и подождать несколько минут. Если обработанный участок побелел, то следует немедленно бежать к врачу, так как это остроконечная кондилома. Однако если цвет не изменился, это не значит, что высыпания не патологичны и не требуют лечения.
Терапия остроконечных кондилом – симптоматическая. Вывести вирус {amp}gt;папилломы человека из организма невозможно, поэтому врачи лишь удаляют его симптоматические проявления – кондиломы. Чаще всего используют хирургические методы: лазер, криодеструкция, электрокоагуляция. Но различные медикаментозные растворы и мази также применяются.
Причины и лечение белых пятен на половом члене
не меньше 2 недель), и имеются сопутствующие признаки, то скорее всего проблема заключается в инфекционной болезни. А вот саму инфекцию поможет определить врач после лабораторных исследований. Если на коже полового органа имеются паразиты, то нужно как можно быстрее начать лечение. Нормальным считается половой орган, на котором отсутствуют любые пятна и выпуклости в виде прыщей.
Хотя, конечно же, существуют и исключения из этого правила — например, наличие родимых пятен и родинок.
Однако за ними тоже нужно постоянно вести наблюдение, т.к. они могут преобразоваться в опухоль злокачественного типа.
Как только родимое пятно или родинка начали изменять форму, увеличиваться или менять цвет, нужно сразу же обратиться в больницу.
Если у юноши начинается период полового созревания, то вполне возможно появление небольших прыщей или пятен белесого цвета. Это только воспаленные сальные железы. В таком случае сильно бояться не нужно.
Белое пятно может появиться не в одном экземпляре. Это может быть россыпь небольших пятен или прыщей белого цвета. Кроме того, могут возникнуть и другие симптомы инфекции. Например, достаточно часто пациент жалуется на шелушение в области паха. В этом случае обязательно нужно проверить пациента на наличие псориаза или экземы.
Очень часто белые пятна сопровождаются неприятными ощущениями, дискомфортом, раздражением, зудом, жжением. Это может указывать на то, что на коже присутствуют паразитические микроорганизмы. Зуд может быть спровоцирован подкожными клещами или вшами. Иногда пятнышки являются признаком аллергии.
Если вместе с пятнами на половом члене появляется не просто дискомфорт, а легкая боль, которая со временем только усиливается, то нужно проверить пациента на наличие кандидоза генитального вида. Такие пятна на внешних половых органах могут возникнуть при передаче бытовым методом, через половой контакт.
Это может быть инфекционное заболевание или воспалительные процессы, которые спровоцированы другими факторами.
Если человек недостаточно следит за чистотой наружных половых органов, то в некоторых случаях на половом члене появляются белые пупырышки. Дело в том, что половые органы выделяют специальное вещество, которое называется смегмой. Это характерно и для мужчин и для женщин.
У смегмы довольно резкий запах, так что если ее не смывать хотя бы один раз в день, то постепенно это вещество будет скапливаться на половом органе и источать неприятных и резкий запах, причем со временем он будет становиться только сильнее. Смегма похожа на творожистое вещество.
Чтобы такое не возникало, необходимо не только каждый день купаться с мылом и промывать половой орган, но и подмываться каждый раз после того, как было осуществлено опорожнение. Для этого лучше подобрать специальные средства по уходу за нежной кожей в интимной зоне, т.к. обычные средства могут сильно сушить ее.
Конечно, кандидоз больше характерен для представительниц женского пола. Однако молочница вполне может развиваться и у мужчин. Инфекция грибкового типа передается при половом контакте. Также заражение может произойти через белье.
Кстати, генитальный кандидоз у мужчин может возникнуть и из-за приема сильнодействующих медикаментов, и хотя это случается достаточно редко, с антибиотиками все равно лучше не шутить. Молочница у мужчин вызывается грибками кандиды.
Налет на половом органе в таком случае не просто белого цвета, но еще и творожистой консистенции, а еще под ним видны покраснения на коже и даже отеки. Пациент испытывает сильный зуд и боли при мочеиспускании.
Пятна белого цвета могут возникнуть из-за развития сахарного диабета. Изменения климатических условий также могут повлиять на это. Еще один фактор — ВИЧ-инфекция. Не стоит исключать и обычное ослабление иммунной системы. Кстати, белые пятна могут появиться и в качестве предракового симптома.
Следует помнить и про гранулы Фордрайса — они не дают секрету выходить наружу.
Каковы бы ни были причины образования налета на половом члене, лечение должно быть незамедлительным. Но лучше всего заблаговременно проводить профилактическое мероприятия, чтобы не допустить появление белых пятен. Во-первых, самое главное правило — это соблюдение основной гигиены.
Необходимо каждый день прочищать наружные половые органы, чтобы на них не скапливался налет. Во-вторых, при половом контакте обязательно нужно использовать защиту. Презервативы помогут предотвратить заражение инфекцией любой природы — грибка, вируса, бактерий. Если появились первые тревожные звоночки, то половые контакты запрещаются.
Партнеры должны обязательно обратиться в больницу.
Иногда причина заключается в длительном и неправильном применении антибиотиков. Чтобы предотвратить подобные процессы, необходимо во время лечебной терапии применять пробиотики. Они помогут восстановить микрофлору кишечника. Кроме того, очень полезно употреблять йогурт, кефир и другие кисломолочные продукты.
Если заболевание имеет грибковую природу, то запрещается употреблять все продукты, приготовленные с добавлением дрожжей. Придется воздержаться от хлеба, хлебобулочных и кондитерских изделий. Кстати, все сладости тоже придется отменить, т.к. сахар в них только способствует развитию грибковой культуры.
Если болезнь находится на ранней стадии, то можно воспользоваться средствами народной медицины. Например, очень эффективными получаются настойки на основе ромашки, корня солодки, календулы и прочих растительных компонентов. Но комплексный подход к лечению даст результат намного раньше, так что лучше подключать и применение аптечных медикаментов.
Существует множество сопутствующих симптомов, которые помогут определить болезнь. Кроме того, обязательно нужно будет сдать анализы для подтверждения диагноза. Только после этого врач сможет назначить медикаменты, которые помогут избавиться от этой проблемы.
Но лучше всего регулярно следить за гигиеной интимной зоны, чтобы минимизировать шансы возникновения подобных инфекций. Можно воспользоваться различными мазями, свечами, гелями, кремами. Также существуют препараты общего действия. Их принимают перорально.
В зависимости от типа инфекции подбирают противомикозные, противововирусные средства или антибиотики. Этим может заниматься только врач. Самолечение в данном случае может навредить.. Белые пятна на члене могут появляться по разным причинам.
Выбор терапии напрямую зависит от фактора, спровоцировавшего образование белых точек на половом органе. Если они являются следствием заболевания, необходимо лечить именно его. В зависимости от этиологии подбирается определенная схема терапии.
- При кандидозе назначается прием противогрибковых препаратов в сочетании с витаминными комплексами. Рекомендуется использовать мазь для местного применения.
- При ВПЧ показана противовирусная терапия, которая направлена на укрепление иммунной системы. Для удаления наростов применяется электрокоагуляция. криодеструкция, лазерным метод.
- ЗППП подлежат лечению грамотно подобранными с учетом болезни антибактериальными средствами. Крайне важно пройти курс терапии полностью с последующим контрольным лабораторным исследованием.
- Аллергические проявления можно устранить с помощью антигистаминных препаратов и витаминных комплексов. Уместной считается обработка антисептическими средствами и растворами. Головку нужно мазать кремом, который наносить тонким слоем.
Важно знать! В случае усиленной работы сальных желез, которая приводит к избыточной выработке секрета, необходимо обратиться к диетологу и изменить рацион питания.
Из ежедневного употребления исключаются жирные, жареные, острые блюда, маринады, копчености, алкоголь, газированные напитки. Под запретом находится фаст-фуд, выпечка и сладости.
Кандидоз у мужчин
Грибы рода Кандида – условно-патогенная флора, вызывающее заболевание лишь при значительном снижении иммунитета. В нормальном состоянии они обитают в ротовой полости и кишечнике у мужчин, а также во влагалище у женщин. Помимо проблем с факторами защиты организма предрасполагающим фактором является сахарный диабет.
Появление белых пятен на головке полового члена – первый признак развития кандидоза. В дальнейшем, при прогрессировании инфекции, пятна будут сливаться, отслаиваться, образуя налет творожистой консистенции. Появляются участки не покрытой эпителием здоровой ткани, которые зудят и пекут. Также характерна боль. Заболевание может сопровождать неожиданной эрекцией.
Главными диагностическими методами кандидоза являются:
- визуальный осмотр;
- выявления возбудителя в мазках (бактериоскопия, бактериология);
- серологические методы;
- полимеразная цепная реакция;
- дополнительные исследования на наличие сопутствующих венерических инфекций (сифилиc, гонорея и т.д.).
Лечение кандидоза комплексное и направленное на борьбу с инфекцией и восстановление иммунологической защиты организма.
Местно применяют успокаивающие ванночки с антисептиками и пораженные участки обрабатывают противогрибковой мазью.
Пятна на члене при аллергических реакциях
При образовании на члене высыпаний в виде розеол или красно белых пятен можно предположить, что организм пациента среагировал на аллерген.
В данном случае высыпания сопровождаются чувством зуда и дискомфорта.
Причиной аллергической реакции могут быть использование косметических средств, латексных презервативов, стиральных средств.
Лечение повышенной чувствительности заключается в приеме антигистаминных препаратов (Лоратадин, Супрастин) и ограничении контакта с аллергеном.
Контагиозный моллюск
Вирус контагиозного моллюска относится к вирусам группы оспы поражает кожные покровы и слизистые оболочки организма.
Путь передачи – контактный, через предметы гигиены и обихода, а также при непосредственном контакте с зараженной поверхностью.
Контагиозный моллюск является причиной появления маленьких белых точек на головке полового члена, однако локализуется он повсеместно, поражая любой участок организма.
Характеристика высыпаний:
- высыпания папулезного характера;
- из субъективных ощущений может присутствовать зуд;
- размер до половины сантиметра;
- имеется пупкообразное вдавление, при нажатии на которое выделяется белое вещество.
Среди атипичных форм контагиозного моллюска различают:
- гигантскую (при размерах высыпаний более сантиметра);
- педикулярную (если морфологический элемент располагается на тонкой ножке);
- милиарную (множество мелких и частых высыпаний).
Методы лечения идентичны тем, которые применяют при остроконечных кондиломах. Также практикуют выдавливание содержимого папул с последующей обработкой антисептиком. Данная терапия не грозит рецидивами, так как моллюск поражает лишь кожные покровы, а не проникает в кровь. Однако заниматься самолечением не следует, чтобы не способствовать распространению инфекции.
Псориаз и пятна на члене
Заболевание имеет неинфекционную природу и поражает кожные покровы, в частности может формироваться на пенисе.Точные причины выявить не удается.
Среди предрасполагающих факторов ведущее место занимают стрессовые ситуации и нервные перенапряжения, гормональный дисбаланс, травмы, снижение иммунный свойств организма.
Чаще псориаз развивается у мужчин от 20 до 40 лет.
Симптомы патологического процесса выглядят следующим образом:
- вначале появляются красные папулы, сливающиеся формирующие бляшки;
- сверху бляшек на половом члене при псориазе образовывается белые шелушащиеся пятна;
- при повреждении высыпаний на пораженном участке проступает кровь, а сами элементы сыпи увеличиваются в размерах;
- при возникновении симптомов на головке пениса шелушение отсутствует;
- дополнительными симптомами являются жжение и покраснение.
Лечение проводится местное с использованием кортикостероидов, антидепрессантов, анксиолитики.
Вылечить полностью псориаз на сегодняшний день не представляется возможным.
Основные симптомы белых пятен
Высыпания на головке полового члена могут появляться вследствие поражения организма венерическими инфекциями и воспалительными заболеваниями мочеполовой системы.
Симптомы:
- зуд, не проходящий в течение недели и более;
- болевые ощущения в паховой области и внизу живота;
- наличие папулезных, возвышающихся над кожей высыпаний;
- общие явления интоксикации и инфицирования в виде слабости и повышения температуры;
- увеличение лимфатических узлов в паховой области или любых нескольких групп;
- болезненные ощущения в области высыпаний;
- изъязвления, не склонные к заживлению.
Наиболее частыми инфекциями, поражающими половой член, являются сифилис и гонорея.
Рассмотрим основные симптомы белых пятен на головке члена. Такими симптомами может быть зуд, боль и наличие белого налёта на пятнах. Могут возникнуть болезненные ощущения во время полового акта.
В большинстве случаев точки и белые пятна на головке обусловлены несоблюдением правил гигиены и ухода за наружными половыми органами. После того, как выделилась смегма из сальных протоков, она скапливается в соответствующей области, а при недостаточной гигиене возникает еще и неприятный резкий запах.
В таком случае белые точки на головке члена возникают без зуда и боли, и не вызывают вред здоровью мужчины. Однако если не проводить систематически водные процедуры, которые позволяют удалить патологический налет, в данной среде начинают скапливаться болезнетворные микроорганизмы, вызывающие воспалительный процесс.
Иная причина возникновения белых точек на головке и крайней плоти – анатомическая особенность мужского организма. В большинстве случаев – это нормальное явление, которое так же не наносит вреда здоровью.
Точки образованы волосяными фолликулами или сальными протоками, которые расположены близко к поверхности кожного покрова. Лечение проводят только при симптомах воспалительного процесса вокруг точек.
Маленькие белые точки под головкой у мужчин – признак дисбаланса в функционировании вегетативной системы. Если не начать своевременно терапию первичной патологии, возникают опасные последствия.
В таком случае могут выступать и красно-белые точки, которые так же считаются нормой, если присутствуют без иных явно выраженных симптомов (зуда, гиперемии, жжения, боли). Лечение проводится неврологом.
Кроме физиологических причин появления фото-симптома (белых точек) на головке полового члена, существуют и патологические, которые выражаются в развитии заболеваний, имеющих схожие проявления.
Определить вид патологии сможет только врач. Единственное, что может сделать больной до похода к урологу, — это запомнить давность возникновения сыпи, сопутствующие симптомы, предшествующие факторы.
Сразу стоит отметить, что это такое явление, которое может сигнализировать о развитии венерического заболевания, в особенности, сифилиса, хламидиоза, генитального герпеса, гонореи.
Если отсутствует зудящий синдром, это указывает на иную патологию, не венерическую. Последняя характеризуется болью при мочеиспускании, выделением желтого экссудата из мочеиспускательного канала, жжением, зудом.
Белые точки на головке – симптом кандидозной инфекции. Несмотря на то, что такая болезнь чаще диагностируется у женщин, она может встречаться и у представителей сильного пола. В данном случае симптом возникает не только на головке, но и пол крайней плотью, на самом столбе.
Иная причина – вирус папилломы человека на члене, который может жить в организме в скрытом состоянии и активизироваться под воздействием провоцирующего фактора (ослабления иммунной защиты, частого переохлаждения и т.д.). Внешний признак патологии – формирование кондилом, имеющих светлый цвет.
Иное вирусное патологическое состояние – контагиозный моллюск. Внешние клинические проявления возникают на кожном покрове полового органа и слизистых оболочках, то есть на головке. Заражение происходит при контакте с носителем вируса или бытовым путем. Белые точки чешутся, а при надавливании образуется светлый экссудат.
Перед тем как определить, чем лечить и как убрать неприятный симптом, врач назначает ряд диагностических мероприятий, которые позволяют поставить правильный диагноз.
В первую очередь проводят осмотр полового члена, определяя характер клинического проявления, его распространенность, сопутствующие симптомы.
Далее проводят лабораторные исследования:
- анализ крови, по результатам которого можно обнаружить развитие воспалительного процесса в организме;
- гистологическое исследование взятого образца биологического материала с поверхности кожного покрова;
- анализ крови на наличие вирусных частиц, характерных для ВИЧ;
- микроскопическое исследование взятого образца биоптата, то есть налета;
- серологический анализ;
- биопсию увеличенного пахового лимфоузла, если такой симптом присутствует.
Как только поставлен окончательный диагноз, назначают соответствующее лечение. В большинстве случаев ограничиваются консервативными методами. При необходимости назначают физиотерапевтические процедуры.
Почему появляются пятна на половом члене?
В норме кожа и слизистая мужского полового органа должны иметь однородную окраску. Но иногда на головке или крайней плоти возникают непонятные пятнышки. Подобное явление может быть обусловлено рядом причин.
Безусловно, собственными силами достаточно сложно определить, чем именно вызваны изменения на коже и слизистых интимных органов. Обнаружив прыщики, пятнышки или красные точки на головке полового члена, лучше проконсультироваться с врачом.
Недостаточная гигиена у мужчин
Удивительно, но многие современные мужчины уделяют собственной гигиене недостаточное внимание или осуществляют элементарные гигиенические мероприятия не слишком правильно, что может привести к возникновению на половом органе разных неприятных изменений. частности, нерегулярное мытье или смена белья чревато развитием раздражения нежных слизистых, из-за чего на коже могут образоваться красноватые пятна, приносящие дискомфорт. Если проигнорировать такую ситуацию, можно столкнуться с довольно сильным воспалением.
Также пятна могут появляться из-за избыточного мытья, но это, скорее, исключение. Хотя урологи настоятельно не рекомендуют мыть головку полового члена мочалкой и обычным мылом, так как они оказывают выраженное раздражающее действие.
Мужчинам следует совершать ежедневный туалет половых органов, а также регулярно менять белье на свежее. При отсутствии доступа к воде можно воспользоваться влажными гипоаллергенными салфетками.
Аллергический дерматит
Чаще всего изолированные аллергические реакции на половом члене возникают при местном влиянии раздражителей (именно на область половых органов). Спровоцировать неприятную симптоматику могут:
- Средства личной гигиены, особенно если в их составе присутствует масса консервантов, отдушек, а также красителей.
- Белье из синтетической ткани. Чаще всего неприятные симптомы аллергии в таком случае появляются у мужчин, которые спят обнаженными.
- Недостаточно выстиранное постельное или нательное белье (если в нем остались частички стирального порошка).
- Лекарственные средства для местного применения. Разнообразные гели, мази и кремы также могут вызвать яркую симптоматику аллергии.
- Средства для интимной жизни. Аллергия может развиться на презервативы, а также женские средства для контрацепции, используемую смазку, ароматизаторы и пр.
Типичные проявления аллергии на половом члене включают в себя красные пятна, некоторую отечность, сыпь и выраженный зуд. При лечении такой проблемы очень важно своевременно выявить фактор, который привел к возникновению неприятной симптоматики, и устранить его.
Красная бляшка при псориазе
Псориаз полового члена — это хронический неинфекционный недуг, причины которого пока неизвестны ученым. Это заболевание, к счастью, не заразно, хотя и может принести много дискомфорта. Развитие болезни может начаться с появления на головке либо на стволе пениса точечных покраснений или сыпи, которая ощутимо чешется. Иногда псориаз прогрессирует очень быстро, и пациент может неожиданно обнаружить на краю полового члена красное пятно с четкими контурами. На нем могут просматриваться чешуйки — свидетельство нарушений в процессе ороговения кожи. Иногда пятно выглядит просто как красная бляшка без шелушений, приподнятая над уровнем здоровой слизистой.
Иногда дерматовенерологи испытывают затруднения в диагностике псориаза на гениталиях, так как при такой локализации болезнь может протекать с нарушенной симптоматикой. Однако все соскобы с пораженного участка показывают отсутствие инфекционных агентов.
Зуд при генитальном герпесе
Герпес на половых органах возникает по причине активности вируса простого герпеса. Заразиться ним можно при половом контакте либо при переносе вирусных частиц с губ (где чаще возникают пузырьки герпеса) или же с предметов общего пользования. Недуг может проявить себя:
- Появлением красных точек на головке и стволе полового органа.
- Возникновением зуда, боли и жжения в месте образования пятен.
- Специфическими выделениями из уретры.
- Увеличением лимфатических узлов.
- Симптомами интоксикации: повышенной температурой, слабостью, ломотой и пр.
Довольно быстро красные пятнышки на слизистых становятся пузырьками. В это время жжение носит особенно выраженный характер. Спустя несколько дней пузырьки лопаются, оставляя после себя корочки, которые отпадают сами по себе.
Генитальный герпес очень заразен. Лечение такой болезни носит симптоматический характер и никак не помогает изгнать вирус из организма.
Пятна и белый налет при молочнице
Кандидоз — это достаточно распространенное грибковое заболевание, которое чаще фиксируется у женщин, нежели у мужчин. Но при наличии предрасполагающих факторов (к примеру, снижения иммунитета) этот недуг вполне может развиться и у представителей сильного пола. Его основной виновник — дрожжеподобные грибки из рода Кандида. При их неумеренном размножении мужчина может столкнуться с характерными симптомами заболевания:
- Возникновением на головке полового члена красных пятен без четко выраженных границ. Такой симптом часто сопровождается отечностью.
- Появлением болезненных ощущений во время мочеиспускания, эрекции, а также полового контакта.
- Возникновением зуда и ощутимого жжения.
- Появлением специфического белого налета, который имеет творожную консистенцию и отличается выраженным кислым запахом.
Появление симптомов молочницы требует консультации с врачом и отказа от половой жизни на весь период лечения. Иногда справиться с болезнью удается лишь при помощи местных лекарств и некоторых изменений образа жизни.
Поражение крайней плоти при баланопостите
В целом термин «баланопостит» используется для обозначения воспалительного процесса, локализующегося на головке полового члена и крайней плоти. Такое состояние может провоцироваться разными бактериями, вирусами и грибками, и часто возникает на фоне разнообразных проблем со здоровьем, которые снижают общую сопротивляемость организма. Типичные симптомы баланопостита:
- Изменения состояния головки полового члена. На ней появляются трещинки и эрозии, красные точки и пятна. Возможно сужение крайней плоти, из-за чего головка обнажается с трудом.
- Несущественные изменения кожи. Возможно появление покраснения и припухлости полового члена.
- Возникновение патологических выделений разного типа, в том числе и гнойных.
Выявить фактор, который привел к развитию баланопостита, и скорректировать его, поможет опытный врач. Попытки самолечения могут привести к развитию хронических проблем со здоровьем и разных осложнений.
Сифилис на мужском органе
На сегодняшний день сифилис является не слишком распространенным венерическим заболеванием, тем не менее при беспорядочных половых связях у мужчины есть риск заразиться ним. Данный недуг вызывается бледной трепонемой и проявляется довольно специфическими симптомами:
- На месте внедрения возбудителя в организм появляется болячка, которая носит наименование сифилома. Ее также называют твердым шанкром. Первичная сифилома выглядит как язва либо эрозия круглой или же овальной формы. Она обладает блестящим и гладким дном. Часто такое новообразование локализуется на головке полового члена либо крайней плоти, но может формироваться и в ротовой полости. Его края несколько приподнимаются над кожей. Такой шанкр не вызывает никакого дискомфорта и боли.
- Спустя несколько дней после формирования первичной сифиломы могут увеличиться лимфатические узлы около места поражения.
- При отсутствии терапии шанкр может исчезнуть без следа, а лимфоузлы — уменьшиться. В дальнейшем недуг может проявить себя сыпью по всему телу разного типа — вторичными сифиломами.
Сифилис сейчас сравнительно легко поддается лечению. Поэтому заподозрив у себя возможное развитие такого недуга, нужно не бояться, а поскорее обращаться за помощью к медикам.
Мелкие остроконечные кондиломы
Кондиломами называют мелкие выросты на коже и слизистых оболочках, которые возникают по причине активности в организме ВПЧ — вируса папилломы человека. Этот возбудитель очень легко передается от человека к человеку, в том числе и во время полового акта. Ученые уверены, что он есть в организме большинства взрослых людей. Но недуг далеко не всегда проявляет себя. Кондиломы могут появляться на теле из-за падения защитных сил организма. Они могут локализоваться:
- Непосредственно на головке либо стволе полового члена.
- На слизистых оболочках внутреннего листка крайней плоти.
- На кожных покровах мошонки либо промежности.
- Около ануса.
Перед появлением явных признаков болезни на коже могут образоваться непонятные пятнышки светло-розовой и красноватой окраски. Со временем они становятся наростами. Сами кондиломы не болят и не чешутся (лишь изредка возникает зуд при их появлении), они выглядят как остроконечные бугорки телесной или розовой окраски, могут несколько увеличиваться в размерах со временем. Однако такие новообразования потенциально опасны с точки озлокачествления, врачи предпочитают удалять их при помощи разных методов воздействия.
Чтобы предупредить повторное появление кондилом проводится иммуноукрепляющее и противовирусное лечение, но полностью изгнать ВПЧ из организма не представляется возможным.
Розовые прыщики при контагиозном моллюске
Контагиозный моллюск — это вирусный недуг, способный передаваться от человека к человеку во время простого контакта (соприкосновения кожи). Такой недуг типичен для детей, но вполне может развиться и у взрослых, например, при снижении иммунитета. Основные проявления такой болезни — высыпания в виде розовых пятен-прыщиков, которые имеют розовую окраску и размер от 1 мм до 1,5 см. Сыпь может появиться на коже спустя несколько недель либо месяцев для инфицирования. Если надавить на один из элементов высыпаний, из него выделиться специфическая густая масса белой окраски.
К сожалению, контагиозный моллюск не лечится какими-то специфическими методами воздействия. Этот недуг требует особенно тщательного соблюдения гигиены и укрепления иммунитета. Проявления заболевания вполне могут исчезнуть сами по себе, но иногда врачи настаивают на их оперативном удалении.
Новообразования
Существует довольно много разновидностей доброкачественных опухолей, которые могут сформироваться на мужском половом органе. Однако куда большую опасность представляет возможные раковые новообразования. Заподозрить онкологию можно по появлению:
- Непонятной сыпи или пятен, которые возникают без видимых причин и не проходят.
- Утолщенного участка кожи.
- Кровоточивости, в том числе и из уретры.
- Язвочки.
- Скопления содержимого под крайней плотью.
- Шишки или бородавки.
Иногда также на рак может указывать припухлость полового члена и увеличение лимфатических узлов в паху.
Конечно, появление описанной симптоматики не говорит на все 100% о развитии рака. Но тем не менее столкнувшись с непонятными признаками, лучше проявить бдительность и проконсультироваться с врачом.
Профилактика
С целью снижения риска появления белых точек на члене необходимо:
- Использовать просторное нательное белье из натуральных тканей для исключения раздражения, опрелостей, нормализации местного воздухообмена.
- Соблюдать интимную гигиену, предусматривающую использование антисептиков, противобактериальных средств (при необходимости).
- Содержать руки в чистоте.
- При пересушенности кожи половых органов применять витаминные увлажняющие кремы.
- Быть предельно осторожным при посещении туалетов, саун, бассейнов общего пользования.
- Пользоваться контрацептивами при каждом сексуальном контакте.
- Укреплять иммунную систему (в том числе, за счет отказа от вредных привычек).
- Периодически обследоваться у врача даже при отсутствии жалоб.
Первичная профилактика инфекций:
- использование презервативов при всех видах полового акта;
- наличие одного надежного партнера для секса;
- аккуратность при посещении тату-салонов и других мест, где возможно заражение с помощью нестерильных инструментов;
- прохождение планового обследования у венеролога;
- поддержание нормального иммунитета.
Так как появление сыпи может быть спровоцировано раздражением, то нужно отдавать предпочтение натуральному нижнему белью. Сбалансированное и здоровое питание также поможет избежать появления сыпи. Противопоказаны выдавливания высыпаний, чтобы не занести инфекцию.
Порядок действий при выявлении пятен
Маленькие белые точки на члене не всегда являются признаком патологии. В большинстве случаев справиться с ними удаётся и без помощи специалиста. При появлении выделений необходимо провести небольшое исследование, обращая внимание на следующие особенности:
Еще интересней:
Язвочка на головке у мужчин фото
Язык при краснухе у детей
- кровяные вкрапления — присутствуют или нет;
- оттенок — зеленоватый, белый, жёлтый, прозрачный;
- структура — творожистая, гелеобразная, жидкая;
- запах — имеется или нет, неприятный или естественный.
Если выделения прозрачные или белые, без кровяных вкраплений и запаха, мужчине не стоит беспокоиться, даже в случае их подсыхания и образования корочек. Для предотвращения возможного инфицирования необходимо тщательно промывать гениталии раз в день, используя специальные моющие средства с нейтральным Ph. После каждого подмывания необходимо производить смену нижнего белья.
В случаях, когда выделения приобретают жёлто-зелёный оттенок или возникает неприятный запах, требуется помощь специалиста (уролога или венеролога). Такие признаки могут сигнализировать о бактериальном поражении половых органов. Специалист установит тип возбудителя, определит источник воспаления и назначит лечение. При появлении примесей крови, а также прочих неприятных ощущений: зуда, болезненности, отёчности, гиперемии, затруднённого мочеиспускания необходимо срочно обратиться к врачу.
Подготовительные мероприятия
Для облегчения симптоматики мужчина может предпринять некоторые действия. Например, перед походом к специалисту разрешается проведение следующих манипуляций:
- обработка полового органа лекарственными растворами — Хлоргексидин, Мирамистин;
- применение детской присыпки, что поможет уменьшить симптоматику;
- промывание пениса с использованием детского мыла или специальных средств для интимной гигиены;
- ванночки с лекарственными растениями: дубовой корой, чередой, ромашкой.
Пятна на члене при герпесе
Вирусное заболевание половых органов передается от зараженного полового партнера и вызывает характерную симптоматику.
При герпесе на половом члене формируются пузырьки, внутри заполненные прозрачной жидкостью, на вид могут напоминать белые пятна.
Спустя некоторое время пузырьки вскрываются и на их месте образовываются язвочки, спустя один-два дня покрывающиеся корочкой.
Вирусное заболевание сопровождается увеличением паховых лимфатических узлов.
За несколько дней до появления первых элементов сыпи в месте поражения возникает зуд и жжение.
Герпетическая инфекция гениталий требует незамедлительного лечения.
В противном случае болезнь может привести к серьезным последствиям в виде поражения ЦНС, развития бактериальных патологий, онкологических заболеваний.
Лечение герпеса проводится с применением противовирусных средств, которые чередуют курсами – Интерферон, Валацикловир, Ацикловир.
Для местного лечения применяется мазь Герпферон.
Как выглядит отрубевидный лишай на члене
Зачастую причиной развития отрубевидного лишая на органах мочеполовой системы является несоблюдение гигиены.
В результате происходит размножение грибковой микрофлоры.
Клиническая картина выглядит следующим образом:
- формируется светло розового оттенка пятно, чаще на головке пениса, но может возникать и на любом другом участке полового члена;
- в дальнейшем пятно может окрашиваться в грязно желтый цвет;
- далее возникают элементы высыпаний;
- появляются белые пятна на половом члене при отрубевидном лишае на головке, которые со временем склоны к шелушению;
- высыпания сопровождаются незначительным жжением и зудом, но чаще болезнь практически не вызывает неприятных ощущений.
Лечение проводится с применением противогрибковых средств местного применения – Ламизил, Низорал.
Что делать, если обнаружено заболевание?
Угри и белые пятна на коже пениса могут быть вызваны различными причинами.
Лечение подбирается индивидуально, зависит это от того, что именно было диагностировано во время обследования. Внимание надо уделить тому, какие симптомы еще наблюдались при появлении таких точек.
Белые пятнышки, которые напоминают внешне угри, являются особенностью строения самой кожи.
Это волосяные фолликулы, сальные железы или потовые, которые выступают на поверхности кожи мошонки, пениса, по всей крайней плоти.
Выдавливать их нельзя, они не вызывают никаких болезненных ощущений. К врачу надо обращаться только в том случае, когда такие железы воспаляются, хотя происходит это крайне редко.
Если белые точки на коже сопровождаются какими-либо проявлениями, включая сильную боль, зуд, отечность, то нужна помощь врача.
Не следует надеяться, что кремы и мази уберут проблему, часто они только снимают внешние проявления, а заболевание, вызвавшее белые точки на коже, переходит в хроническую форму. Тогда лечить их становится сложно.
Белые пятна и точки могут быть вызваны витилиго. Это заболевание может возникнуть в любом возрасте.
Если кожа вдруг покрылась полосами и пятнами белого цвета, а врач поставил именно такой диагноз, то это свидетельствует о нарушениях обмена веществ.
Назначается специальная диета, препараты для повышения иммунитета, специальный курс лечения для нормализации обменных процессов организма.